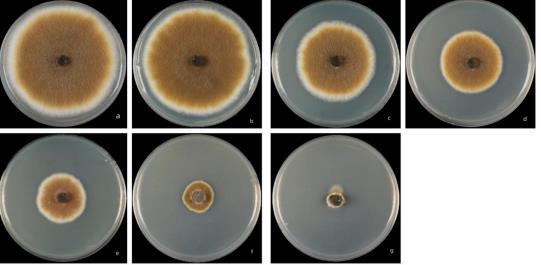

菌核凈與解淀粉芽孢桿菌Cas02生長曲線繪制,篩選出煙草赤星病防治效果更好的復配劑
煙草是一種重要的經濟作物,也是我國主要的稅收經濟作物之一。煙草在大田生長過程中會受到各種病原菌的侵染、危害,其中由半知菌亞門鏈格孢屬真菌鏈格孢菌(Alternaria alternata)引起的赤星病是一種重要侵染性病害。赤星病主要發生在煙草成熟期,侵染初期在葉片上出現黃褐色圓形小斑點,以后變成褐色,隨著病害擴展病斑直徑可達1-2厘米,病斑質脆易破,天氣干旱時有可能在病斑中部產生破裂。病害嚴重時,許多病斑相互連接合并,致使病斑枯焦脫落,進而造成整個葉片破碎而無使用價值。
煙草赤星病的防治主要包括化學防治、農業防治和生物防治等幾種方法,其中化學防治見效快,是目前主要的赤星病防治方法,但化學農藥的長期大量使用會導致病原菌產生抗藥性,同時藥劑殘留對環境的危害不容小覷。生物防治因其安全、對環境友好等特點而被廣泛關注,尤其是利用生防菌進行病害的防控是當前研究的熱點。
利用生防菌防控植物病害是一種環境友好、安全高效的方法,生防菌在植物葉際、根際等部位定殖后可以形成穩定的群落,提供持續的防病作用,減少病害的反復發生。此外,一些生防菌具有廣泛的防治譜,能夠同時抑制多種植物病原菌。與化學農藥相比,生防菌由于其作用機制多樣,病原微生物產生抗藥性的風險相對較低。但是利用生防菌進行病害也存在一些弊端,如生防菌見效慢、活性易受環境因素影響,防治效果可能出現波動等問題。
生防菌和化學藥劑通過不同的機制作用于病原體,聯合使用可以實現互補作用,提高防治效果。聯合使用還可以減少化學藥劑的使用量,延緩病原體對藥劑產生抗性的速度,延長藥劑的有效期。生防菌不僅可以直接抑制病原體,還能夠激發植物的抗病性,增強植物自身的防御能力,這種誘導抗性的作用是化學藥劑難以實現的。此外,減少化學藥劑的使用量有助于降低農藥殘留和環境污染,符合可持續農業發展的要求。然而,使用生防菌-化學藥劑協同防治煙草赤星病的方法少有研究報道。
研究發現,菌核凈與解淀粉芽孢桿菌Cas02對煙草赤星病菌均有較高的毒力,同時生長曲線表明兩者具有很好的相容性。且復配劑使用比單獨使用防治效果好,產生了良好的協同防治作用。針對現有技術的不足,下面提供解淀粉芽孢桿菌聯合菌核凈在防治煙草赤星病中的應用。
篩選防治煙草赤星病的高效、安全的復配劑,上述技術方案采用菌絲生長速率法測定菌核凈與解淀粉芽孢桿菌Cas02對煙草赤星病菌(Alternaria alternata)的毒力,通過繪制生長曲線測定兩者之間的相容性。通過測定兩者不同復配比例對煙草赤星病菌的聯合毒力以及室內盆栽防效試驗篩選防治效果更好的復配劑。

由圖2解淀粉芽孢桿菌Cas02的生長曲線可知,加入菌核凈抑制中濃度與不加菌核凈的NB培養基中培養的Cas02生長情況基本一致,說明該濃度下菌核凈與Cas02相容性很好,可進行復配。
結果表明,菌核凈與解淀粉芽孢桿菌Cas02對煙草赤星病菌均有較高的毒力,EC50值分別為4.86μg/mL和OD600值為0.4916。生長曲線表明兩者具有很好的相容性。除復配比例V(菌核凈):V(Cas02)為1:9,8:2,9:1時沒有協同增效作用,其它比例均具有不同增效作用。其中,增效作用最好的是7:3,增效比率為1.32,實際抑菌率達到67.61%。室內盆栽試驗結果表明,兩種復配比例間差異不顯著,但是復配劑使用比單獨使用防治效果好,復配劑V(菌核凈):V(Cas02)=7:3時病情指數最低,與CK呈顯著差異,防治效果最好,達到75.71%。
上述技術方案操作步驟簡單,可操作性強,成本低,便于推廣實施,同時對煙草赤星病的防治效果極佳,具有良好的實際應用價值。
相關新聞推薦
2、DNA甲基化是什么意思?DNA甲基化轉移酶與生長抑制(一)
3、豨薟草果實內生細菌分離、鑒定、生長特性、抑菌效果及藥敏分析(一)
